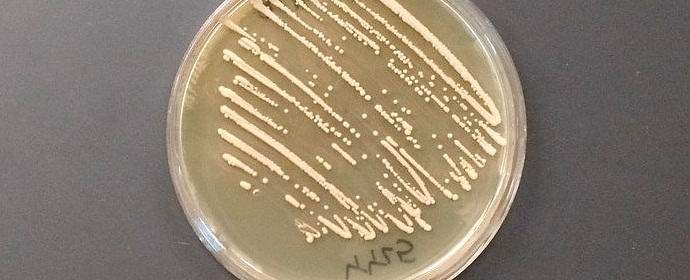
Američané chovali kvasinky, které přeměňují cukr v opium

Foto z otevřených zdrojů Skupina vědců ze Stanfordské univerzity vedená Dr. Christina Smallová přinesla jedinečný kmen kvasnice. Tyto jednobuněčné houby jsou schopné proměnit cukr v ne ethylalkohol a na opioidy. Stále podobné léky látky lze získat výhradně z máku opia. Ne není divu, že objev Američanů se stal téma vzrušené debaty a diskuse.
Foto z otevřených zdrojů Skupina vědců ze Stanfordské univerzity vedená Dr. Christina Smallová přinesla jedinečný kmen kvasnice. Tyto jednobuněčné houby jsou schopné proměnit cukr v ne ethylalkohol a na opioidy. Stále podobné léky látky lze získat výhradně z máku opia. Ne není divu, že objev Američanů se stal téma vzrušené debaty a diskuse.
Specialisté objevili ne náhodou, ale záměrně. Vědci zamýšleli získat opium houba tak, aby mohla být použita ve farmaceutických přípravcích zejména vytvořit levné léky proti bolesti a léky proti kašli.
Je třeba poznamenat, že podobné studie již byly provedeny. Například v roce 2005 skupina odborníků z University of Berkeley změnou kvasinkových genů vytvořil lék, který se stal základem pro artemisinin – prostředek k boji proti malárii. Artemisinin nahradil chinin extrahovaný z pelyněk a demonstroval vysoká účinnost při léčbě komplikovaných a těžkých forem malárie.
 Foto z otevřených zdrojů
Foto z otevřených zdrojů
Mnoho mezinárodních vědců vyjádřilo obavy nový americký vývoj. Lze je chápat jako podobné inovace mohou zásadně změnit světový obchod s drogami – účinnost získaných kvasinek je stotisíckrát vyšší než účinnost mák opium! Pokud obchodníci s drogami získají technologii, opium mohou být levnější a dostupnější než kdykoli předtím, zejména ve srovnání s jinými drogami.
Je však příliš brzy na to mluvit, protože Američané přinese své kvasinky ještě několik let technologie na mysli. Kromě toho zástupci americké zpravodajské služby uvedl, že přijmou veškerá bezpečnostní opatření houba nebyla ve špatných rukou.
 Foto z otevřených zdrojů
Foto z otevřených zdrojů






